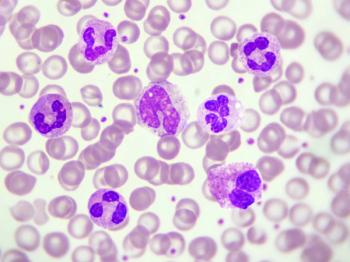

The BASECAMP-1 study is identifying patients with human leukocyte antigen (HLA) loss of heterozygosity (LOH) for future use of these therapies.

The BASECAMP-1 study is identifying patients with human leukocyte antigen (HLA) loss of heterozygosity (LOH) for future use of these therapies.

Three patients dosed had tumors shrinkages of 18%, 21%, and 27%.

Data from the IMA203 trial were presented at the SITC 2021 annual meeting.

Sonny Hsiao, PhD, chief executive officer, president and cofounder, Acepodia, discussed the company’s future research and plans.

TCR² Therapeutics is collaborating with Bristol Myers Squibb to evaluate combination therapies in a phase 2 trial.

Primary efficacy data released by Sangamo Therapeutics showed that above normal α-Gal A activity was maintained for up to a year after treatment.

4D Molecular Therapeutics announced positive data from trials assessing 2 of their gene therapies.

Paul Lammers, MD, MSc, president and chief executive officer, Triumvira Immunologics, discussed the challenges of manufacturing cell therapies.

The vaccination therapy improved progression-free survival by 3.1 months over standard care in 1 patient treated.

Partners in the Bespoke Gene Therapy Consortium include the NIH, FDA, private companies such as Pfizer and Biogen, and non-profits.

The phase 1 study of NTLA-2001 previously showed positive interim data, including serum TTR reductions, which were reported in June 2021.

The FDA cleared the IND application for HMI-203 in October 2021.

Dabocemagene autoficel has previously received orphan drug, rare pediatric disease, fast track, and regenerative medicine advanced therapy designations.

Homology is also developing a gene therapy, HMI-102, being evaluated in the phase 1/2 pheNIX trial.

VM202 was found to be particularly effective in treating neuroischemic ulcers.

bluebird bio is also planning to withdraw the marketing authorization for their β-thalassemia therapy, beti-cel, from the EU and UK.

The phase 1/2 SUNRISE trial is now enrolling patients as young as 6 months old with methylmalonic acidemia after positive review under a DSMB.
Rocket Pharmaceuticals announced positive data on RP-L201 in leukocyte adhesion deficiency-I, as well as RP-A501 for Danon disease.

AVROBIO shared interim safety data from ongoing phase 1 and 2 trials.

The patient’s daily insulin requirement went from 34 units a day at baseline to 2.9 units a day 90 days after treatment.

The collaboration combines AdAlta’s i-bodies and Carina Biotech’s chemokine receptor platform.

Results from a phase 1/2 study from Nanoscope Therapeutics were presented at the 2021 ASRS meeting.

The study follows Legend Biotech’s initial success with cilta-cel, whose PDUFA date is set for November 2021.

Enrollment in the CARBON trial has so far focused on aggressive disease such as diffuse B-cell lymphoma.

REGENXBIO previously announced positive data in patients with wet AMD who were treated with the same gene therapy.

Sarepta Therapeutics has also initiated the pivotal phase 3 EMBARK study in pediatric patients with DMD.

Intellia Therapeutics is also initiating a phase 1/2 study of a CRISPR therapy for hereditary angioedema in New Zealand.

ALVR109, another of AlloVir’s T-cell therapies, also recently showed efficacy in treating COVID-19 in high-risk patients.

Allogene continues to investigate and characterize the chromosomal abnormality and its relationship to the gene editing.

Thorsten Graef, MD, PhD, chief medical officer, Acepodia, discussed data on ACE1702 presented at ESMO 2021.